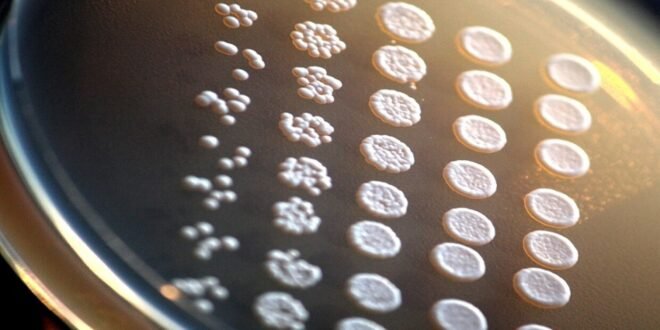

منبر العراق الحر :
حقق الباحثون من جامعة “ماكواري” في أستراليا إنجازا مهما في علم الأحياء الاصطناعية، حيث قاموا لأول مرة في التاريخ بتجميع الكروموسومات الـ16 لجينوم الخميرة بشكل كامل.
وتعد مهمة تصنيع وتجميع كل الكروموسومات الـ16 للخميرة بشكل صحيح تحديا كبيرا، حيث لا يتطلب ذلك إعادة بناء الحمض النووي الخاص بها، فحسب بل وضمان عملها داخل الخلية الحية.
وتمكن العلماء إلى حد الآن من إنشاء جينومات اصطناعية للبكتيريا البسيطة فقط. أما الآن، فقد تمت إعادة برمجة الجهاز الجيني الكامل للخميرة التي تُستخدم على نطاق واسع في صناعات الأغذية والأدوية والتكنولوجيا الحيوية.
ولتحقيق ذلك، قام الباحثون بتصنيع وتجميع الكروموسوم الأخير (SynXVI)، لكنهم واجهوا عدة مشاكل قبل ذلك:
أولا – من أجل جعل الجينوم يعمل، كان لا بد من “ضبطه” مثل برنامج كمبيوتر. واستخدم العلماء تقنية CRISPR الخاصة بالتعديل الجيني التي تسمح بتعديل الحمض النووي للكائنات بدقة عالية من خلال قطع أو استبدال أو إضافة الجينات المطلوبة لتصحيح الأخطاء.
ثانيا – وإضافة إلى ذلك فإن الخميرة الاصطناعية واجهت صعوبة في استخدام الجلسرين كمصدر للطاقة عند التسخين، لكن العلماء تمكنوا من حل هذه المشكلة.
ثالثا – كما كانت هناك مشكلة أخرى تتمثل في تحسين العلامات الجينية، وهي عملية تحديد مواقع أجزاء خاصة من الحمض النووي تساعد في تتبع وإدارة عمل الجينات. واكتشف الباحثون أن وضع هذه العلامات بشكل غير صحيح يمكن أن يعطل عمل الخلايا، مما يؤثر على تنشيط الجينات المهمة.
وقالت عالمة الأحياء الجزيئية والمشاركة في البحث ساكي بريتوريوس: “هذه نقطة فارقة في علم الأحياء الاصطناعية، لقد وجدنا جوهر المشكلة بعد مرور سنوات عديدة. ويعتبر ذلك اختراقا كبيرا في مجال قدرات الهندسة الوراثية”.
وأضاف العلماء أن هذا المشروع لا يقتصر على الزراعة فقط، إذ أن الحمض النووي الاصطناعي يمكن أن يسرع إنتاج الأدوية، ويزيد من مقاومة النباتات للتغيرات المناخية، وحتى إنشاء مواد حيوية جديدة.
المصدر:مجلة Nature Communications العلمية.
 منبر العراق الحر منبر العراق الحر
منبر العراق الحر منبر العراق الحر